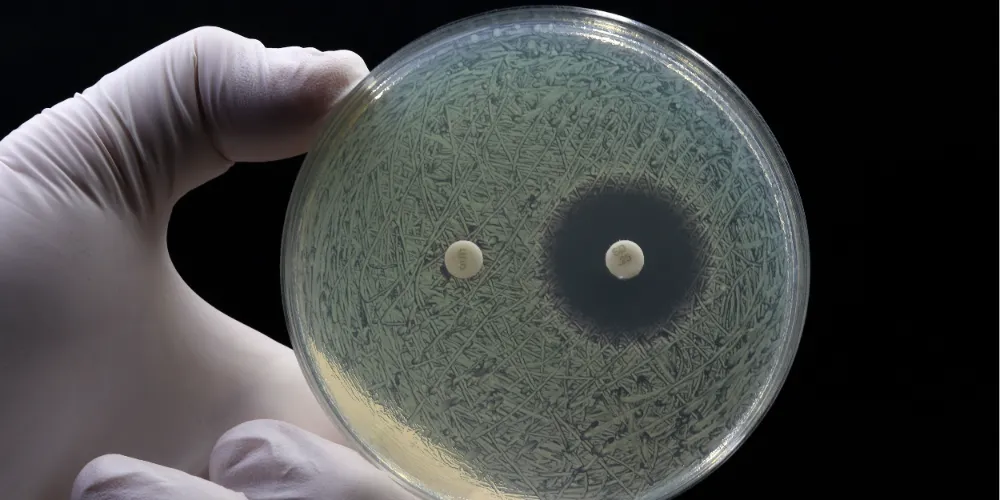

ANTİBİYOTİK DİRENCİ, SALMONELLA ENFEKSİYONLARINI DAHA TEHLİKELİ HALE GETİRİYOR
Salmonella enfeksiyonlarında antibiyotik direncinin dünya genelinde ciddi bir halk sağlığı tehdidi olabileceğini belirten Prof. Dr. Müzeyyen Mamal Torun, kritik uyarılarda bulundu.
-
A+Buyut
-
A-Kucult
Torun, "Artık bazı salmonella türleri üç ya da daha fazla antibiyotiğe karşı dirençli. Bu da tedaviyi zorlaştırıyor ve komplikasyonları artırıyor" dedi.
Salmonella ve Salmonelloz hakkında bilgi veren Biruni Üniversitesi Tıp Fakültesi Tıbbi Mikrobiyoloji Anabilim Dalı Başkanı Prof. Dr. Müzeyyen Mamal Torun, "Gram negatif bir bakteri olan salmonella, hem hayvanlarda hem insanlarda enfeksiyonlara neden olabiliyor. Salmonella cinsinde, Salmonella bongori ve Salmonella enterica olmak üzere iki tür bulunur. Salmonella bongori esas olarak soğukkanlı hayvanlarda bulunmasına karşın insanları da enfekte edebilir. Yaygın olarak bulunan S. enterica, insanlarda ve hayvanlarda çok çeşitli gıda ve su kaynaklı enfeksiyonlara neden olur. S. enterica, 2600'den fazla serotip içerir ve dünya genelinde (tifo hariç) S. enterica serotip Typhimurium ve S. enterica serotip Enteritidis alt serotipleri insanlardan en sık izole edilen (yaklaşık yüzde 50) patojenlerdir" diye konuştu.
Gıda kaynaklı bulaşmanın yaygın olduğunu belirten Prof. Dr. Müzeyyen Mamal Torun, çiğ veya az pişmiş et ve kümes hayvanları, yumurta, süt ve süt ürünleri, yeşil yapraklı sebzeler ve pastörize edilmemiş meyve sularının en riskli besin grupları arasında yer aldığını ifade etti.
Prof. Dr. Müzeyyen Mamal Torun, "Yıkanmamış sebzeler, az pişmiş kümes hayvanı eti, pastörize edilmemiş süt ve çiğ yumurta gibi gıdalar salmonella ile kontamine olabilir. Ayrıca, kontamine su, hayvan teması ve uluslararası seyahatler de enfeksiyonun bulaşmasında etkili olabilir" uyarısında bulundu.
Her yıl milyonlarca kişiyi etkiliyor
Prof. Dr. Müzeyyen Mamal Torun, dünya genelinde her yıl yaklaşık 93,8 milyon Salmonella kaynaklı gastroenterit vakası ve 155 bin ölüm bildirildiğini söyledi. Türkiye'de de geçmiş yıllarda fıstıklı kakaolu kremalar, kumpir ve bazı çikolatalar, Sezar salata sosu gibi çiğ veya az pişmiş yumurta içeren yiyecekler, sashimi ve suşi dahil olmak üzere çiğ veya az pişmiş balık veya kabuklu deniz ürünleri aracılığıyla salgınların yaşandığını belirten Torun, bu bakterinin sadece bireysel sağlığı değil, toplum sağlığını da tehdit ettiğini vurguladı.
Prof. Dr. Torun, Salmonella enfeksiyonunun her yaş grubunu etkileyebileceğini ancak özellikle küçük çocuklar, yaşlılar, bağışıklık sistemi zayıf olanlar ve hamileler için daha tehlikeli olduğunu söyledi.
Antibiyotik direnci artıyor
Prof. Dr. Torun, özellikle son yıllarda antibiyotik direncinin Salmonella vakalarında belirgin şekilde arttığına dikkat çekerek, Avrupa’da 2022 yılında Salmonellaların, florokinolonlara yüzde 18.7, azitromisine yüzde 0.6 ve üçüncü kuşak sefalosporinlere yüzde 12 oranında direnç geliştirdiğini bildirdi. Torun, "Avrupa’da insanlardan izole edilen salmonella türlerinde çoklu ilaç direncinin (MDR) yüzde 22’ye kadar ulaştığı hayvan kaynaklı bakterilerde ise bu oran yüzde 40’lara yaklaşıyor" dedi.
Dirençli bakterilerin oluşturduğu enfeksiyonlarda tedavinin zorlaştığını, daha uzun süren enfeksiyonlara ve artan ölüm riskine neden olduğunu ifade eden Torun, "XDR (yaygın ilaç dirençli) ve PDR (tüm antibiyotiklere dirençli) bakteriler artık nadir de olsa karşımıza çıkabiliyor" dedi.
Direncin başlıca nedenleri
Antibiyotiklerin tarımda ve hayvanların beslenmesi sırasında büyümeyi destekleyici olarak kullanılması, sağlık alanında gereksiz ve kontrolsüz antibiyotik tüketimi ve hijyen eksikliğinin bu direncin başlıca nedenleri arasında yer aldığını belirten Torun, "Hastalara tanı konulmadan rastgele antibiyotik verilmesi dirençli bakteri türlerinin çoğalmasına zemin hazırlıyor" diye konuştu.
Korunma için çapraz bulaşma önlenmeli
Salmonella enfeksiyonlarından korunmak için başta hijyen kurallarına dikkat edilmesi gerektiğini belirten Prof. Dr. Torun, şu önerilerde bulundu:
“Çiğ ve pişmiş gıdalar ayrılmalı, çapraz bulaşma önlenmelidir. Et ve yumurta gibi ürünler yeterince pişirilmelidir. Meyve ve sebzeler iyice yıkanmalıdır. Soğuk zincir bozulmamalıdır. Hayvanlarla temastan sonra eller mutlaka yıkanmalıdır”
Antibiyotik duyarlılık testi önemli
Salmonella gastroenteritlerinin tedavisinde, hastaların çoğu sadece destekleyici bakım tedavisine ihtiyaç duyduğunu dile getiren Prof.Dr. Mamal Torun, "Antibiyotik tedavisine ihtiyaç duyulan durumlarda; önerilen birinci basamak antibiyotiklerden florokinolonlar (siprofloksasin), azitromisin ve üçüncü kuşak sefalosporinler (seftriakson, sefotaksim) kullanılabilir. Ancak antibiyotik direncini önlemek ve antibiyotik seçimini en doğru şekilde yapmak için önce duyarlılık testi yapılması gereklidir" ifadesini kullandı.
Tifo için kullanılan Ty21a aşısının yalnızca Salmonella Typhi’ye karşı koruma sağladığını hatırlatan Torun, "Ancak bu aşılar tüm salmonella türlerine karşı etkili değildir.
Salmonella enfeksiyonlarının bildiriminin Türkiye’de yasal zorunluluk kapsamında olduğunu söyleyen Prof. Dr. Torun, "Tifo ve paratifo gibi enfeksiyonlar 24 saat içinde Sağlık Bakanlığı’na bildirilmelidir. Gastroenterit yapan diğer türler için ise haftalık sürveyans kaydı yapılmalıdır" dedi.
“Akılcı antibiyotik kullanımı hayati önemde”
Prof. Dr. Torun, salmonella gibi dirençli bakterilerle mücadelede One Health (Tek Sağlık) yaklaşımının önemine vurgu yaparak, "İnsan, hayvan ve çevre sağlığını birlikte düşünmeliyiz. Tarımda, veterinerlikte ve tıpta antibiyotiklerin akılcı kullanımı sağlanmadan bu sorunun üstesinden gelmek mümkün değil" dedi.
“Toplum bilgilendirilmeli, sistem denetlenmeli”
Salmonella’nın yol açtığı sağlık sorunlarını azaltmak için sadece bireysel değil, toplumsal önlemler gerektiğini vurgulayan Torun, "Gıda üreticileri denetlenmeli, etiketleme sistemi güçlendirilmeli, halk bilinçlendirilmeli ve antibiyotik kullanımına ilişkin yasal düzenlemeler sıkılaştırılmalıdır" diyerek sözlerini tamamladı.
Niğde’de Bayramda Binlerce Personel Görevde
Vali Akmeşe Şehit Aileleri ve Gazilerle Buluştu
Niğde’de İlahi Konseriyle Manevi Yolculuk
Memurlara Bayram İkramiyesi Çağrısı
Niğde’de Gıda Denetimleri Ramazan Öncesi Yoğunlaştırıldı
Niğde’de Çanakkale Deniz Zaferi’nin 111. yılı Anıldı
Çanakkale Ruhu Altunhisar’da Yaşatıldı
Narkotik Ekiplerinden Zehir Operasyonu
Niğde’de 18 Mart Törenlerle Anılacak
Murtaza Köyü’nde Öğrencilerle İftar Buluşması
Vali Akmeşe’den 18 Mart Mesajı: “Çanakkale Geçilmez”
Niğde’de Ceza Yağdı: 2 Bin 364 Sürücüye İşlem
Altunhisar’da Özel Bireylerle Ramazan Sofrası Kuruldu
Niğde'de çevreci ulaşım dönemi başladı
Niğde Esnafına TAPDK Uyarısı: 31 Mart Son Gün
Bayram Öncesi Araç Bakımı Hayati Önemde
NİĞDEF’ten 160 Yetim Çocuğa İftar Programı
Bayram Tedbirleri Görüşüldü
Sağlık Çalışanları Masa Tenisiyle Stresi Attı
Bülent Şen: “Vatandaş Mağdur Ediliyor”
BBP Niğde İl Başkanı Karataş’tan Milli Marş Tepkisi
Niğde’de Gençler İslam İlmihali Bilgilerini Yarıştıracak
Niğdeli Kardiyoloğa “Yılın Doktoru” Ödülü
Niğde Çiftlik’te Uyuşturucu ve Silah Operasyonu
Niğde’de Uyuşturucu ve Kumarla Mücadele İçin Kritik Toplantı
Bolat: “Türkiye çevresindeki savaşlara rağmen büyümeyi sürdürdü”
Niğde’de Şehit Kabirlerine Ziyaret
Niğde Mezarlıkları Bayrama Hazır
Niğde’de Gümrükleme Dönemi Başlıyor
Niğde’de Elektrikli Otobüsler Ücretsiz Hizmete Giriyor
Yükleniyor

- Perşembe 10 ° / 4.9 ° Bölgesel düzensiz yağmur yağışlı
- Cuma 9.6 ° / 3.9 ° Bölgesel düzensiz yağmur yağışlı
- Cumartesi 8.6 ° / 1.8 ° Bölgesel düzensiz yağmur yağışlı



